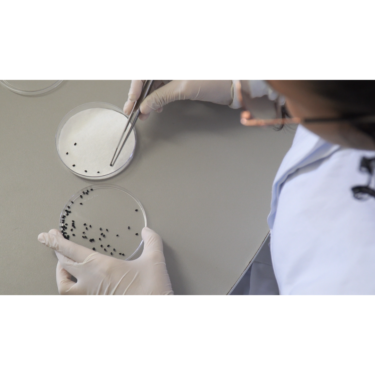

PESQUISA REALIZADA NO CENTRO UNIVERSITÁRIO ANALISA A CITOTOXICIDADE DO CHÁ DE ALFAZEMA
segunda-feira, 19 de agosto de 2024.
A Profa. Dra. Lilia Rosário Ribeiro juntamente da aluna Jayane Lopes Rodrigues, do 3º período do curso de Biomedicina, estão realizando uma pesquisa sobre o tema “Análise de citotoxicidade do chá de alfazema (Lavandula officinalis L.)”.
O projeto avalia a seguridade do uso de plantas medicinais pela população. No Brasil, assim como em países emergentes, as pessoas têm o hábito de utilizar plantas medicinais para tratamento de doenças. Contudo, esse uso pode não trazer apenas benefícios, pois as plantas podem produzir diversos compostos que podem se diluir no chá e gerar malefícios ao consumidor. A lavanda ou alfazema tem sido muito utilizada na medicina popular para tratar problemas de digestão e de ansiedade.
Para realizar o projeto, a professora pesquisadora explicou que utilizam um bioensaio chamado Allium cepa, que é reconhecido mundialmente para a detecção de substâncias com potencial citotóxico. A pesquisa utiliza análise microscópica para identificar se a exposição ao chá induz algum dano ao ciclo celular e ao material genético dessa espécie. Ao final das análises, se não houve nenhum dano nessa exposição, é um indicativo de que o uso do chá é seguro. Por outro lado, se houver algum tipo de alteração, as pessoas precisam ter cautela quanto ao consumo da planta.
A docente enfatizou ainda que os resultados obtidos contribuirão para a conscientização da população, pois as plantas possuem diversos compostos que podem ser benéficos ou prejudiciais. Ter esse conhecimento contribui no discernimento do consumo.
No campus já foram feitas pesquisas similares com outras espécies de plantas que retornaram um resultado inesperado. A Profa. Dra. Lilia Rosário Ribeiro ressalta como exemplo o uso do funcho, conhecido por atuar no tratamento de recém nascidos que apresentam flatulência, e, segundo ela, a maioria das pessoas não tem conhecimento de que a folha desta planta apresenta alto nível de toxicidade conforme resultado da pesquisa realizada.
Para os alunos, a participação na Iniciação Científica os capacita para a participação em eventos científicos, aperfeiçoa a capacidade da escrita, da fala em público e proporciona ambientação e prática de laboratórios.
A aluna Jayane Lopes Rodrigues é bolsista pelo Conselho Nacional de Desenvolvimento Científico e Tecnológico (CNPq) e conta que é a sua primeira participação em uma pesquisa. Ela comentou sobre a sua experiência: “É muito interessante porque acredito que o projeto em si traz uma vivência acadêmica significativa, além da prática, porque possibilita muita experiência no laboratório. Vemos coisas que às vezes a gente não vê na faculdade em si porque não aborda essa parte nas matérias, então podemos descobrir diversas áreas, além de adquirir experiência no laboratório como o manuseio do microscópios, a confecção de lâminas, o manuseio de vidrarias e o preparo de soluções”.
“Começando na Iniciação Científica você pode contribuir para a sociedade, para a sua formação acadêmica, para o mercado de trabalho, e pode ser uma pessoa mais capacitada. É muito bom fazer iniciação”, disse Jayane Lopes Rodrigues.
A Profa. Dra. Lilia Rosário Ribeiro atua no UNIFOR-MG há 22 anos como professora e como pesquisadora há mais de 20 anos. Durante seu mestrado e seu doutorado ela trabalhou com a linha de pesquisa “Citogenética Vegetal” e atualmente ampliou seus estudos para a área de Citotoxicidade.
“A pesquisa sempre traz esse viés científico com a possibilidade de devolutiva para a população de algo que seja de interesse, como é o caso do uso das plantas medicinais”, ela disse.